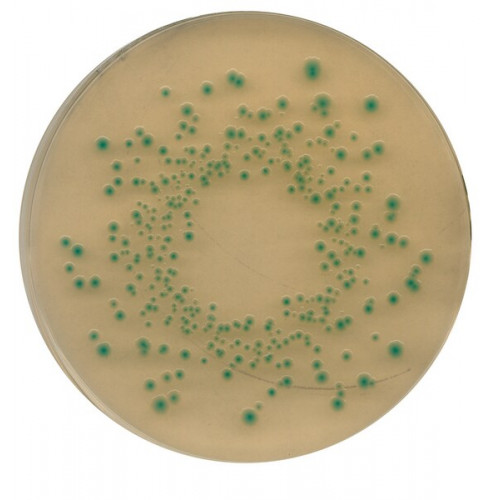

CHROMOCULT TBX (TRYPTONE BILE X-GLUCURONIDE) AGAR 500GR MERCK
Modelo: 1161220500
-
R$9.114,21
ou até 3x de R$3.038,07 sem juros
Economize 5% no PIX: R$8.658,50
ou 3.5% no boleto: R$8.795,21
Consulte aqui o valor do frete e prazo de entrega
Descrição
CHROMOCULT TBX (TRYPTONE BILE X-GLUCURONIDE) AGAR MERCK
RENDIMENTO 36,6g/l MEIO GRANULADO SEG. ISO 16649
EMBALAGEM 500GR
Agar seletivo para detecção e enumeração de Escherichia coli em gêneros alimentícios, comida animal e água.
O meio está de acordo com as recomendações da ISO16649-2, 2000.
Com substrato cromogênico X-GLUC (5-bromo-4-chloro-3 indolyl b-D-glucuronate).
Mode of Action
The presence of the enzyme b-D-glucuronidase differentiates most E. coli ssp. from other coliforms. E. coli absorbs the chromogenic substrate 5-bromo-4-chloro-3-indolyl-b-Dglucuronide (X-b-D-glucuronide). The enzyme b-glucuronidase splits the bond between the chromophore 5-bromo-4-chloro-3-indolyle- and the -D-glucuronide. E. coli colonies are coloured blue-green.
Growth of accompanying Gram-positive flora is largely inhibited by the use of bile salts and the high incubation temperature of 44°C.
Typical Composition (g/litre)
Peptone 20.0; bile salts No. 3 1.5; X-b-D-glucuronide 0.075; agar-agar 15.0.
Preparation
Suspend 36.6 g in 1 litre of demin. water by heating in a boiling water bath or in flowing steam until the medium is completely dissolved. Autoclave at 121 °C for 15 min. Cool to 45-50 °C in a water bath, mix gently and pour 15 ml in sterile Petridishes.
pH: 7.2 ± 0.2 at 25 °C.
The prepared medium is clear and yellowish. If stored at +2 to +8°C and protected from light plates or medium in bottles are stable for 4 weeks.
RENDIMENTO 36,6g/l MEIO GRANULADO SEG. ISO 16649
EMBALAGEM 500GR
Agar seletivo para detecção e enumeração de Escherichia coli em gêneros alimentícios, comida animal e água.
O meio está de acordo com as recomendações da ISO16649-2, 2000.
Com substrato cromogênico X-GLUC (5-bromo-4-chloro-3 indolyl b-D-glucuronate).
Mode of Action
The presence of the enzyme b-D-glucuronidase differentiates most E. coli ssp. from other coliforms. E. coli absorbs the chromogenic substrate 5-bromo-4-chloro-3-indolyl-b-Dglucuronide (X-b-D-glucuronide). The enzyme b-glucuronidase splits the bond between the chromophore 5-bromo-4-chloro-3-indolyle- and the -D-glucuronide. E. coli colonies are coloured blue-green.
Growth of accompanying Gram-positive flora is largely inhibited by the use of bile salts and the high incubation temperature of 44°C.
Typical Composition (g/litre)
Peptone 20.0; bile salts No. 3 1.5; X-b-D-glucuronide 0.075; agar-agar 15.0.
Preparation
Suspend 36.6 g in 1 litre of demin. water by heating in a boiling water bath or in flowing steam until the medium is completely dissolved. Autoclave at 121 °C for 15 min. Cool to 45-50 °C in a water bath, mix gently and pour 15 ml in sterile Petridishes.
pH: 7.2 ± 0.2 at 25 °C.
The prepared medium is clear and yellowish. If stored at +2 to +8°C and protected from light plates or medium in bottles are stable for 4 weeks.